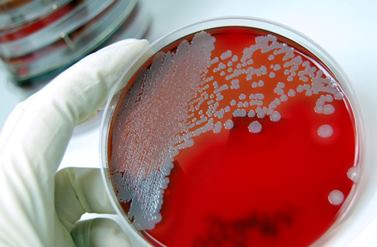

Вопрос, что такое нейроинфекция, начинает мучить больного после постановки подобного диагноза и как правило, ничего хорошего такой диагноз не сулит. Как правило, нейроинфекции головного мозга вызываются всевозможными микроорганизмами, которые поражают как сам головной мозг, так и остальные составляющие центральной или периферической нервной системы, но, обо всем по порядку…
Общие сведения и классификация
Болезни, которые входят в группу нейроинфекционных недугов и их классификация зависит от нескольких факторов, в частности, в зависимости от зоны поражения нейроинфекция головного мозга затрагивает:
- ткани головного мозга (энцефалит);
- спинной мозг (миелит);
- паутинную оболочку головного мозга (арахноидит);
- оболочки головного мозга (менингит);
- корешки головного или спинного мозга (радикулит);
- периферические нервы (полиневрит);
- несколько вышеперечисленных зон (менингоэнцефалит).
Кроме того, болезнь подразделяется по времени протекания на:
- Острая.
- Подострая.
- Хроническая (иногда именуются – медленные нейроинфекции).
К острым типам болезни относят:
- энцефалит;
- менингит;
- столбняк;
- бешенство;
- миелит;
- арахноидит.
К хроническим типам, в свою очередь, относят:
- нейросифилис;
- нейроСПИД;
- проказа;
- нейробруцеллез;
- бруцеллез.
Кроме того, болезнь разделяется на:
- Первичную.
- Вторичную
Первичная инфекция характеризуется возникновением болезни вследствие поражения того или иного отдела головного мозга инфекционным или вирусным возбудителем извне. Возникновение вторичного типа инфекции провоцируется болезнью, имеющейся в организме пациента (туберкулез, сифилис, токсоплазмоз и т. д.).
Смотреть видео: Головной мозг при нейроинфекции

Нейроинфекция представляет собой серьезное заболевание, которое затрагивает центральную нервную систему и может иметь различные причины, включая вирусные и бактериальные инфекции. Врачи подчеркивают, что ранняя диагностика и адекватное лечение играют ключевую роль в восстановлении здоровья пациента. После перенесенной нейроинфекции многие сталкиваются с долгосрочными последствиями, такими как головные боли, нарушения памяти и эмоциональные расстройства. Специалисты рекомендуют комплексный подход к реабилитации, включающий медикаментозное лечение, физиотерапию и психологическую поддержку. Важно не терять надежду и активно участвовать в процессе восстановления, так как многие пациенты способны вернуться к полноценной жизни. Врачи советуют также поддерживать здоровый образ жизни, что способствует улучшению общего состояния и повышению качества жизни.

Симптомы
Вирусная нейроинфекция является обобщенным названием ряда заболеваний, поражающих центральную нервную систему (ЦНС) человека и характерные симптомы нейроинфекции схожи с симптомами болезней, указанных выше.
Основные симптомы недуга:
- головная боль (особенно в утреннее время в лежачем положении);
- общая слабость;
- температура;
- расстройство сознания;
- тошнота;
- рвота;
- повышенная утомляемость;
- галлюцинации;
- отсутствие аппетита;
- расстройство ЖКТ;
- несвязная речь;
- нарушение органов зрения, слуха и обоняния;
- увеличение числа сосудистых сокращений;
- уменьшение нижней отметки артериального давления.
Помимо прочего, у больного могут быть диагностированы вялые парезы нижних конечностей. При надавливании на пораженные конечности пациент будет чувствовать острую боль.
Разновидности заболеваний
Итак, наиболее распространенными нейроинфекциями являются менингит, арахноидит и энцефалит.
Нейроинфекция — это серьезное заболевание, которое поражает центральную нервную систему и может иметь тяжелые последствия. Люди, столкнувшиеся с этой проблемой, часто делятся своими переживаниями и опытом. Многие отмечают, что важным шагом на пути к восстановлению является поддержка близких. Они подчеркивают, что моральная поддержка и понимание со стороны родных помогают справиться с эмоциональными трудностями.
Также пациенты говорят о необходимости комплексного подхода к лечению, включая медикаментозную терапию и реабилитацию. Некоторые делятся историями о том, как занятия спортом и творчеством помогли им восстановить уверенность в себе и улучшить качество жизни. Важно помнить, что каждый случай индивидуален, и путь к выздоровлению может быть долгим, но с правильной поддержкой и настойчивостью можно преодолеть трудности и вернуться к полноценной жизни.

Менингит
Заболевание в результате которого поражается спинной или головной мозг. Заражение происходит воздушно-капельным путем, а также с помощью крови. Основными возбудителями являются вирусы, бактерии и грибки.
Различают несколько видов менингита
- герпесный менингит (герпесвирусная нейроинфекция);
- серозный менингит;
- ветряночный менингит;
- гнойный менингит;
- туберкулезный менингит;
- бактериальный менингит.
У каждой из разновидностей данной болезни существуют особые симптомы, но также имеются и общая симптоматика, в том числе:
- ригидность мышц;
- менингеальные симптомы;
- высокая температура.
Арахноидит
Данное заболевание поражает исключительно паутинную оболочку мозга и развивается в результате перенесенных травм головы, наличия запущенных ЛОР инфекций.
Для данного недуга характерны следующие симптомы:
- тошнота;
- высокая температура;
- рвота;
- болезненное состояние;
- головная боль;
- потеря сознания;
- ухудшение зрения.
Данное заболевание, как и менингит поддается лечению, однако, чем позже поставлен диагноз, тем тяжелее могут быть последствия.
Энцефалит
Данное заболевание, как правило, переносится клещами и является довольно серьезным недугом. Болезнь поражает ткани головного мозга и при отсутствии должного лечения вызывает смерть.
Основной симптомокомплекс включает:
- высокая температура;
- тошнота;
- головная боль;
- нарушения, характерные для органов зрения.
Энцефалит имеет неблагоприятные последствия, даже после окончания лечебной терапии.
Под прицелом ребенок
В особую категорию следует выделить нейроинфекции у детей. В силу того, что малыши обладают менее сильным иммунитетом, они наиболее часто подвергаются опасным заболеваниям. Наиболее характерным недугом является герпесвирусная нейроинфекция и ветряночный менингит. Остальные формы менингита также могут встретиться у ребенка, но не так часто, как вышеперечисленные.
Кроме того, нейроинфекции у детей тяжелее поддаются диагностике. Это обусловлено тем, что ребенок просто не в состоянии объяснить, что его беспокоит. В результате затягивается начало лечения и возможно, появление опасных последствий.
Диагностика и лечение
Важно понимать, что для назначения качественного лечения необходимо проведение своевременной диагностики болезни и определить ее истинную составляющую.
Любая нейроинфекция определяется комплексной диагностикой, в том числе:
- Магнитно-резонансная томография (МРТ);
- Компьютерная томография (КТ);
- Энцефалограмма головы (ЭЭГ).
Помимо прочего, доктор назначает больному сдачу анализов:
- крови;
- мочи;
- спинномозговой жидкости.
Важно: зачастую 40% информации дает анализ ликвора спинномозговой жидкости
Лечение
Лечение проводится строго в стационарных условиях и длиться не менее одной недели, в большинстве случаев больше.
Какие лекарства назначают больному?
В первую очередь проводится антибиотикотерапия. Причем вид антибиотика и дозировку назначает лечащий врач. Как правило, лекарство вводят больному внутривенно либо напрямую в спинной мозг (при воспалениях спинного мозга).
Дополнительно больному назначается курс витаминов, имуноподдерживающая терапия, а также комплекс гормональных средств.
Кроме того, при возникновении осложнений (отек мозга и т. п.) пациенту вводят препараты, устраняющие то или иное осложнение.
Остаточные явления после перенесенного заболевания могут долечиваться дома, при условии удовлетворительного общего состояния пациента.
Что после
Последствия нейроинфекций бывают различными. В зависимости от времени начала лечения и типа перенесенной болезни. В основном они относятся к такому разделу медицины, как неврология.
В частности:
- периодические головные боли;
- чувствительность некоторых органов к перемене погоды;
- нарушения слуха, обоняния или зрения;
- проблемы с запоминанием.
В редких случаях человек становиться инвалидом.
Итак, чем дольше происходит затягивание с обращением к специалисту, тем страшнее последствия могут развиться в итоге. Не стоит играть со своим здоровьем и здоровьем своих детей, берегите себя.
Вопрос-ответ
Каковы последствия нейроинфекции?
Последствия перенесенной нейроинфекции зависят от вида заболевания и времени начала лечения. У пациентов может остаться головная или спинная боль, усиливающаяся при изменениях погоды. После выздоровления может ухудшиться память, зрение или слух. На фоне нейроинфекций могут активироваться сопутствующие заболевания.
Как лечится нейроинфекция?
По возможности проводится специфическое лечение возбудителя инфекции. С этой целью врачи используют антибиотики в таблетках и для инъекционного введения, противогрибковые и противопротозойные препараты. Для большинства вирусных нейроинфекций отсутствуют этиотропные лекарства.
Как понять, что у тебя нейроинфекция?
Нейроинфекция может проявляться различными симптомами, такими как головная боль, высокая температура, рвота, спутанность сознания, судороги, слабость или потеря чувствительности. Если вы заметили сочетание этих признаков, особенно после перенесенных инфекций или травм головы, следует немедленно обратиться к врачу для диагностики и лечения.
Как можно заразиться нейроинфекцией?
Острые нейроинфекции у детей развиваются вследствие попадания в организм патогенных вирусов. Вызвать заболевание могут вирусы обыкновенного герпеса, аденовирусы, энтеровирусы и т. д. Заражение осуществляется через грязные руки, предметы или воздушно-капельным путем.
Советы
СОВЕТ №1
Изучите информацию о нейроинфекциях. Понимание природы заболевания, его симптомов и методов лечения поможет вам лучше справляться с последствиями и принимать обоснованные решения о своем здоровье.
СОВЕТ №2
Обратитесь к специалистам. Если у вас есть подозрения на нейроинфекцию или вы уже столкнулись с ней, важно получить консультацию невролога или инфекциониста. Они помогут вам разработать индивидуальный план лечения и реабилитации.
СОВЕТ №3
Поддерживайте здоровый образ жизни. Правильное питание, регулярные физические нагрузки и достаточный сон способствуют укреплению иммунной системы и могут помочь в восстановлении после нейроинфекции.
СОВЕТ №4
Не забывайте о поддержке близких. Общение с родными и друзьями может оказать значительное влияние на ваше эмоциональное состояние. Не стесняйтесь делиться своими переживаниями и получать поддержку от окружающих.